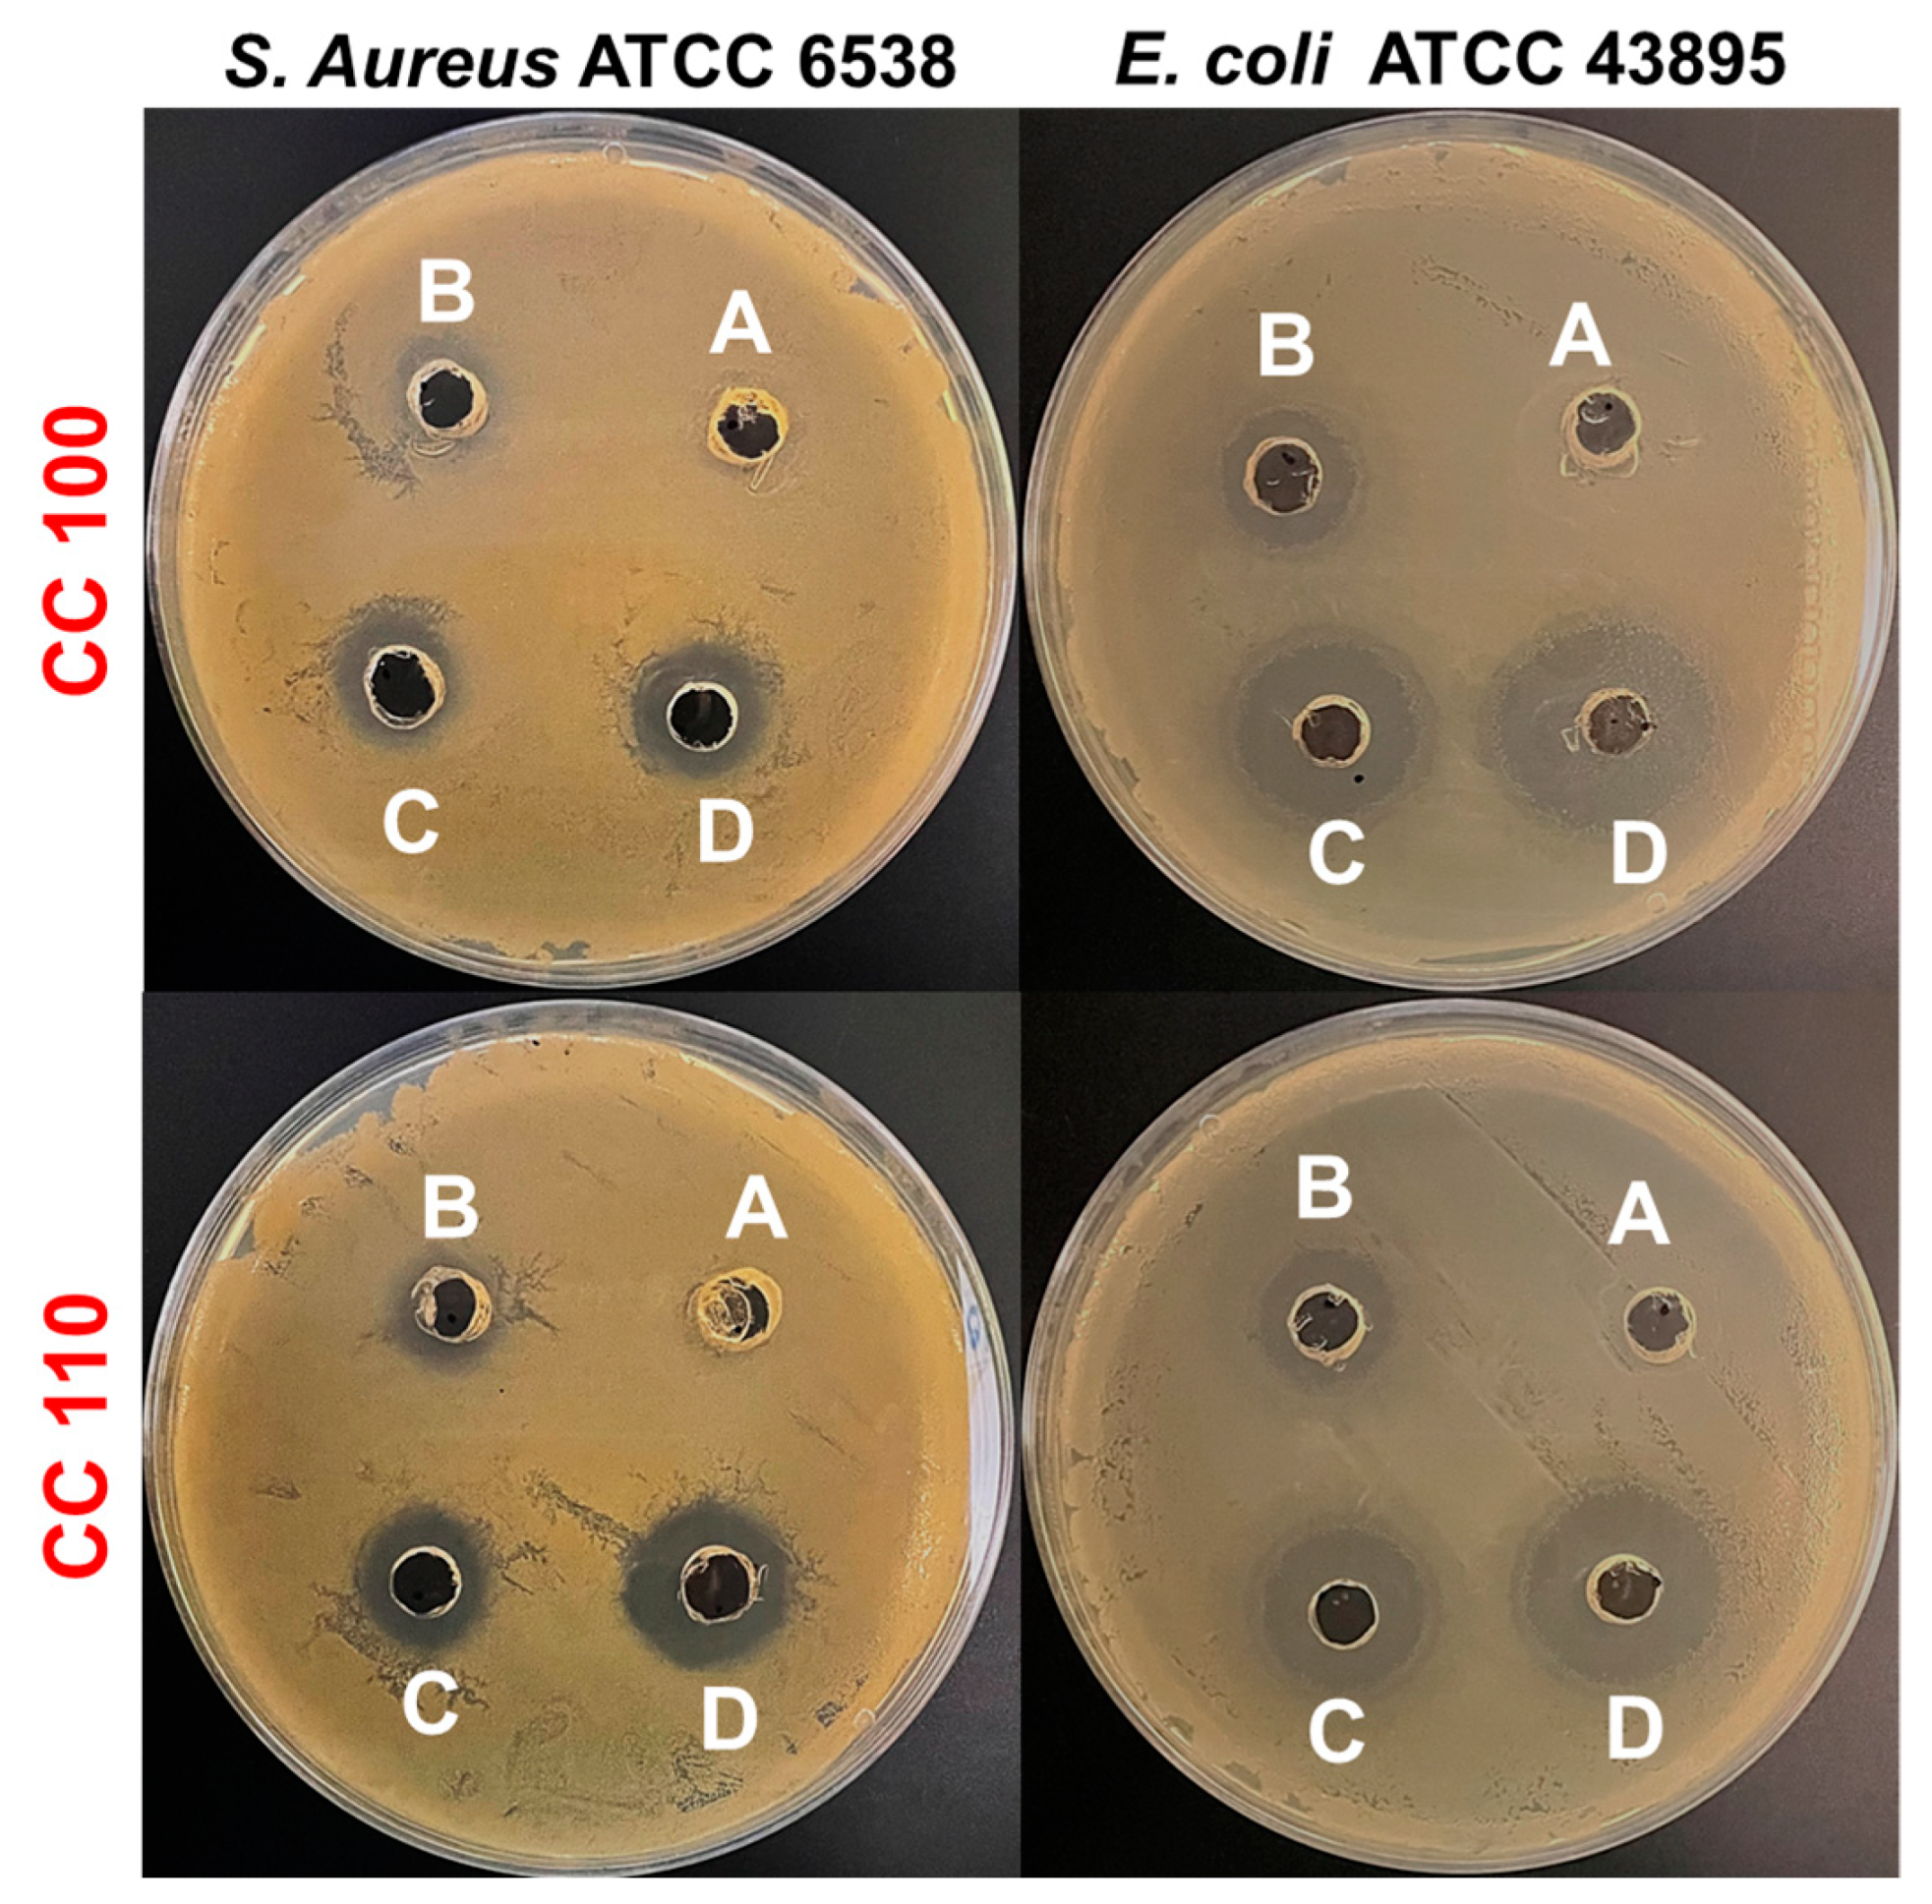
Micromachines 14 00456 g010 Micromachines 14 00456 g010

Novel Microwave Synthesis of Copper Oxide Nanoparticles and Appraisal of the Antibacterial Application
Abstract
1. Introduction
2. Materials and Methods
2.1. Antibacterial Activity and Safety Assessment of CuO NPs
2.1.1. In-Vitro Antibacterial Efficacy
2.1.2. Seed Germination Toxicity Assessment of CuO NPs
3. Results and Discussion
3.1. XRD Analysis of Green Synthetic CuO NPs
3.2. FE-SEM Analysis of Green Synthetic CuO NPs
3.3. HR-TEM Analysis of Green Synthetic CuO NPs
3.4. XPS Analysis of Green Synthetic CuO NPs
3.5. BET Surface Area Analysis
3.6. Raman Spectral Analysis of Green Synthetic CuO NPs
3.7. FT-IR Spectral Analysis of Green Synthetic CuO NPs
3.8. DRS Analysis of Green Synthetic CuO NPs
3.9. TGDTA Analysis of CuO NPs
3.10. Antibacterial Efficacy of CuO NPs
3.11. Safety Profiles of CuO NPs
4. Conclusions
Supplementary Materials
Author Contributions
Funding
Institutional Review Board Statement
Informed Consent Statement
Data Availability Statement
Conflicts of Interest
References
- Bayda, S.; Adeel, M.; Tuccinardi, T.; Cordani, M.; Rizzolio, F. The History of Nanoscience and Nanotechnology: From Chemical–Physical Applications to Nanomedicine. Molecules 2020, 25, 112. [Google Scholar] [CrossRef]
- Ravishankar Rai, V.; Jamuna Bai, A. Nanoparticles and Their Potential Application as Antimicrobials. In Food Preservation; Academic Press: Cambridge, MA, USA, 2011; Volume 197, pp. 567–601. [Google Scholar]
- Jiaxiu, W.; Markus, E.; Kolja, O.; Kai, Z. Biobased materials for food packaging. J. Biores. Bioprod. 2022, 7, 1–13. [Google Scholar]
- Maruthupandy, M.; Anand, M.; Maduraiveeran, G.; Suresh, S.; Hameedha Beevi, A.S.; Jeeva Priya, R. Investigation on the electrical conductivity of ZnO nanoparticles-decorated bacterial nanowires. Adv. Nat. Sci. Nanosci. Nanotechnol. 2016, 7, 045007. [Google Scholar] [CrossRef]
- Dhineshbabu, N.R.; Rajendran, V.; Nithyavathy, N.; Vetumperumal, R. Study of structural and optical properties of cupric oxide nanoparticles. Appl. Nanosci. 2016, 6, 933. [Google Scholar] [CrossRef]
- Zhang, H.; Ji, Z.; Xia, T.; Meng, H.; Low-Kam, C.; Liu, R.; Pokhrel, S.; Lin, S.; Wang, X.; Liao, Y.-P.; et al. Use of Metal Oxide Nanoparticle Band Gap to Develop a Predictive Paradigm for Oxidative Stress and Acute Pulmonary Inflammation. ACS Nano 2012, 6, 4349–4368. [Google Scholar] [CrossRef]
- Franke, M.E.; Koplin, T.J.; Simon, U. Metal and metal oxide nanoparticles in chemiresistors: Does the nanoscale matter? Small 2006, 2, 36–50. [Google Scholar] [CrossRef]
- Liu, X.; Iocozzia, J.; Wang, Y.; Cui, X.; Chen, Y.; Zhao, S.; Li, Z.; Lin, Z. Noble metal–metal oxide nanohybrids with tailored nanostructures for efficient solar energy conversion, photocatalysis and environmental remediation. Energy Environ. Sci. 2017, 10, 402. [Google Scholar] [CrossRef]
- You, J.; Chen, C.C.; Dou, L.; Murase, S.; Duan, H.S.; Hawks, S.A.; Xu, T.; Son, H.J.; Yu, L.; Li, G.; et al. Metal Oxide Nanoparticles as an Electron-Transport Layer in High-Performance and Stable Inverted Polymer Solar Cells. Adv. Mater. 2012, 24, 5267. [Google Scholar] [CrossRef]
- Rastogi, A.; Zivcak, M.; Sytar, O.; Kalaji, H.M.; He, X.; Mbarki, S.; Brestic, M. Impact of Metal and Metal Oxide Nanoparticles on Plant: A Critical Review. Front. Chem. 2017, 5, 78. [Google Scholar] [CrossRef]
- Santos, C.S.C.; Gabriel, B.; Blanchy, M.; Menes, O.; García, D.; Blanco, M. Industrial applications of nanoparticles—A prospective overview. Mater. Today Proc. 2015, 2, 456–465. [Google Scholar] [CrossRef]
- Battu, D.; Vajja, S.; Hariram, N.; Anumakonda, V. Preparation and properties of cellulose nanocomposite fabrics with in situ generated silver nanoparticles by bioreduction method. J. Bioresour. Bioprod. 2021, 6, 75–81. [Google Scholar]
- Nair, P.M.; Chung, I.M. Impact of copper oxide nanoparticles exposure on Arabidopsis thaliana growth, root system development, root lignificaion, and molecular level changes. Environ. Sci. Pollut. Res. Int. 2014, 21, 12709–12722. [Google Scholar] [CrossRef]
- Shaw, A.K.; Ghosh, S.; Kalaji, H.M.; Bosa, K.; Brestic, M.; Zivcak, M. Nano-CuO stress induced modulation of antioxidative defense and photosynthetic performance of syrian barley (Hordeum vulgare L.). Environ. Exp. Bot. 2014, 102, 37–47. [Google Scholar] [CrossRef]
- Honglin, H.; Farhan, U.; Dao-Xiu, Z.; Ming, Y.; Yu, Z. Mechanisms of ROS. Regulation of Plant Development and Stress Responses. Front. Plant Sci. 2019, 10, 800. [Google Scholar]
- Song, G.; Hou, W.; Gao, Y.; Wang, Y.; Lin, L.; Zhang, Z. Effects of CuO nanoparticles on Lemna minor. Bot. Stud. 2016, 57, 3. [Google Scholar] [CrossRef]
- Ku, C.H.; Yang, H.H.; Chen, G.R.; Wu, J.J. Wet-Chemical Route to ZnO Nanowire-Layered Basic Zinc Acetate/ZnO Nanoparticle Composite Film. Cryst. Growth Des. 2008, 8, 283–290. [Google Scholar] [CrossRef]
- Muthukumaran, S.; Gopalakrishnan, R. Structural, FTIR and photoluminescence studies of Cu doped ZnO nanopowders by co-precipitation method. Opt. Mater. 2012, 34, 1946–1953. [Google Scholar] [CrossRef]
- Pooja, R.; Gurjot, K.; Venkateswara Rao, K.; Jagpreet, S.; Mohit, R. Impact of Green Synthesized Metal Oxide Nanoparticles on Seed Germination and Seedling Growth of Vigna radiata (Mung Bean) and Cajanus cajan (Red Gram). J. Inorg. Organomet. Polym. Mater. 2020, 30, 4053–4062. [Google Scholar]
- He, C.; Sasaki, T.; Shimizu, Y.; Koshizaki, N. Synthesis of ZnO nanoparticles using nanosecond pulsed laser ablation in aqueous media and their self-assembly towards spindle-like ZnO aggregates. Appl. Surf. Sci. 2008, 254, 2196–2202. [Google Scholar] [CrossRef]
- Ameer, A.; Arham, S.A.; Oves, M.; Khan, M.S.; Adnan, M. Size-dependent antimicrobial properties of CuO nanoparticles against Gram-positive and -negative bacterial strains. Int. J. Nanomed. 2012, 7, 3527–3535. [Google Scholar]
- Hina, Q.; Sumbul, R.; Dushyant Kumar, C.; Ashok Kumar, T.; Vikramaditya, U. Green Synthesis, Characterization and Antimicrobial Activity of Copper Oxide Nanomaterial Derived from Momordica charantia. Int. J. Nanomed. 2020, 15, 2541–2553. [Google Scholar]
- Jeronsia, J.E.; Joseph, L.A.; Vinosha, P.A.; Mary, A.J.; Das, S.J. Camellia sinensis leaf extract mediated synthesis of copper oxide nanostructures for potential biomedical applications. Mater. Today Proc. 2019, 8, 214–222. [Google Scholar] [CrossRef]
- Yang, N.; Weihong, L.; Hao, L. Biosynthesis of Au nanoparticles using agricultural waste mango peel extract and its in vitro cytotoxic effect on two normal cells. Mater. Lett. 2014, 134, 67–70. [Google Scholar] [CrossRef]
- Rajaram, R.; Lee, Y.K. Microwave-assisted synthesis of copper oxide nanoparticles by apple peel extract and efficient catalytic reduction on methylene blue and crystal violet. J. Mol. Struct. 2023, 1276, 134803. [Google Scholar]
- Yang, B.; Qi, F.; Tan, J.; Yu, T.; Qu, C. Study of green synthesis of ultrasmall gold nanoparticles using Citrus sinensis peel. Appl. Sci. 2019, 9, 2423. [Google Scholar] [CrossRef]
- Gangapuram, B.R.; Bandi, R.; Alle, M.; Dadigala, R.; Kotu, G.M.; Guttena, V. Microwave assisted rapid green synthesis of gold nanoparticles using Annona squamosa L peel extract for the efficient catalytic reduction of organic pollutants. J. Mol. Struct. 2018, 1167, 305–315. [Google Scholar] [CrossRef]
- Mahmoud, N.; Fatemeh, G.; Zahra, I.; Mohammad, S. Recent developments in the biosynthesis of Cu-based recyclable nanocatalysts using plant extracts and their application in the chemical reactions. Chem. Rec. 2019, 19, 601–643. [Google Scholar]
- Mohamed, A.A.; Abu-Elghait, M.; Ahmed, N.E.; Salem, S.S. Eco-friendly mycogenic synthesis of ZnO and CuO nanoparticles for in-vitro antibacterial, antibiofilm, and antifungal applications. Biol. Trace Elem. Res. 2021, 199, 2788–2799. [Google Scholar] [CrossRef]
- Raorane, C.J.; Raj, V.; Lee, J.-H.; Lee, J. Antifungal activities of fluoroindoles against the postharvest pathogen Botrytis cinerea: In vitro and in silico approaches. Int. J. Food. Microb. 2022, 362, 109492. [Google Scholar] [CrossRef]
- Saranya, S.; Agneeswaran, R.; Deepa, P. Green-synthesized rice-shaped copper oxide nanoparticles using caesalpinia bonducella seed extract and their applications. ACS Omega 2020, 5, 1040–1051. [Google Scholar]
- Prasanta, S.; Mitali, S.; Debasish, M. Microwave synthesis of copper oxide nanoparticles using tea leaf and coffee powder extracts and its antibacterial activity. J. Nanostruct. Chem. 2014, 4, 86. [Google Scholar]
- Kenneth, S.; Denis, K.B.; Martin, K.A.; Eddie, M.W.; Francis, E.; Edward, N.; Malik, M.; Juliet, S.; John, B.K. Phyto-Mediated Copper Oxide Nanoparticles for Antibacterial, Antioxidant and Photocatalytic Performances. Front. Bioeng. Biotechnol. 2022, 10, 820218. [Google Scholar]
- Chandan, T.; Indranirekha, S.; Moushumi, H.; Manash, R.D. Reduction of aromatic nitro compounds catalyzed by biogenic CuO nanoparticles. RSC. Adv. 2014, 4, 53229–53236. [Google Scholar]
- Ehsan, A.; Mohammad, H.; Reza, S.; Maryam, S. Copper plasmon-induced Cu-doped ZnO-CuO double-nanoheterojunction: In-situ combustion synthesis and pho-to-decontamination of textile effluents. Mat. Res. Bull. 2020, 129, 110880. [Google Scholar]
- Issaabadi, Z.; Nasrollahzadeh, M.; Sajadi, S.M. Green synthesis of the copper nanoparticles supported on bentonite and investigation of its catalytic activity. J. Clean. Prod. 2017, 142, 3584–3591. [Google Scholar] [CrossRef]
- Hammad, E.N.; Salem, S.S.; Zohair, M.M.; Mohamed, A.A.; El-Dougdoug, W. Purpureocillium lilacinum mediated biosynthesis copper oxide nanoparticles with promising removal of dyes. Biointerf. Res. Appl. Chem. 2022, 12, 1397–1404. [Google Scholar]
- Qiuli, Z.; Zhimao, Y.; Bingjun, D.; Xinzhe, L.; Yingjuan, G. Preparation of copper nanoparticles by chemical reduction method using potassium borohydride. Trans. Nonferrous. Mat. Soc. China 2010, 20, s240–s244. [Google Scholar]
- Cornell, R.M.; Schwertmann, U. The Iron Oxides Structure, Properties, Reactions Occurrences and Uses; Wiley-VCH: Weinheim, Germany, 1996. [Google Scholar]
- Ismail, M.; Khan, M.I.; Khan, S.B.; Khan, M.A.; Akhtar, K.; Asiri, A.M. Green synthesis of plant supported Cu single bond Ag and Cu single bond Ni bimetallic nanoparticles in the reduction of nitrophenols and organic dyes for water treatment. J. Mol. Liq. 2018, 260, 78–91. [Google Scholar] [CrossRef]
- Yadav, D.; Subodh, S.K.A. Recent advances in the design, synthesis and catalytic applications of triazine-based covalent organic polymers. Mater. Chem. Front. 2022, 6, 1574–1605. [Google Scholar] [CrossRef]
- Arif Khan, M.; Nafarizal, N.S.; Mohd, K.A.; Chin, F.S. Surface Study of CuO Nanopetals by Advanced Nanocharacterization Techniques with Enhanced Optical and Catalytic Properties. Nanomat 2020, 10, 1298. [Google Scholar] [CrossRef]
- Shinde, S.K.; Dubal, D.P.; Ghodake, G.S.; Fulari, V.J. Hierarchical 3D-flower-like CuO nanostructure on copper foil for supercapacitors. RSC. Adv. 2014, 5, 4443–4447. [Google Scholar] [CrossRef]
- Vaseem, M.; Hong, A.R.; Kim, R.T.; Hahn, Y.B. Copper Oxide Quantum Dot Ink for Inkjet-Driven Digitally Controlled High Mobility Field Effect Transistors. J. Mater. Chem. C 2013, 1, 2112–2120. [Google Scholar] [CrossRef]
- Mugundan, S.; Rajamannan, B.; Viruthagiri, G.; Shanmugam, N.; Gobi, R.; Praveen, P. Synthesis and characterization of undoped and cobalt-doped TiO2 nanoparticles via sol–gel technique. Appl. Nanosci. 2015, 5, 449. [Google Scholar] [CrossRef]
- Govindaraj, R.; Pandian, S.M.; Ramasamy, P.; Mukhopadhyay, S. Sol-gel synthesized mesoporous anatase titanium dioxide nanoparticles for dye sensitized solar cell (DSSC) applications. Bull. Mater. Sci. 2015, 38, 291. [Google Scholar] [CrossRef]
- Manikandan, B.; Rita, J. Impact of Ni metal ion concentration in TiO2 nanoparticles for enhanced photovoltaic performance of dye sensitized solar cell. Mater. Sci. Mater. Electron. 2021, 32, 5295–5308. [Google Scholar]
- Christoph, B. Modeling of type IV and V sigmoidal adsorption isotherms. Phys. Chem. Chem. Phys. 2019, 21, 5614–5626. [Google Scholar]
- Tomonori, O.; Shotaro, Y.; Tetsuya, K.; Kenji, H. Changing Water Affinity from Hydrophobic to Hydrophilic in Hydrophobic Channels. Langmuir 2015, 31, 1058–1063. [Google Scholar]
- Benhammada, A.; Trache, D.; Chelouche, S.; Mezroua, A. Catalytic Effect of green Cu2O nanoparticles on the thermal decomposition kinetics of ammonium perchlorate. Z Anorg. Allg. Chem. 2021, 647, 312–325. [Google Scholar] [CrossRef]
- Karthikeyan, B. Raman spectral probed electron–phonon coupling and phonon lifetime properties of Ni-doped CuO nanoparticles. Appl. Phys. A 2021, 127, 205. [Google Scholar] [CrossRef]
- Angeline Mary, A.P.; Thaminum Ansari, A.; Subramanian, R. Sugarcane juice mediated synthesis of copper oxide nanoparticles, characterization and their antibacterial activity. J. King Saud Univ. Sci. 2019, 31, 1103–1114. [Google Scholar] [CrossRef]
- Mohammad, S.D.; Mostafa, Z.M. Experimental study of water-based CuO nanofluid flow in heat pipe solar collector. J. Therm. Anal. Cal. 2019, 137, 2061–2072. [Google Scholar]
- Maji, S.K.; Mukherjee, N.; Mondal, A.; Adhikary, B.; Karmakar, B. Chemical synthesis of mesoporous CuO from a single precursor: Structural, optical and electrical properties. J. Solid State Chem. 2010, 183, 1900–1904. [Google Scholar] [CrossRef]
- Lin, H.-H.; Wang, C.-Y.; Shih, H.C.; Chen, J.-M.; Hsieh, C.-T. Characterizing well-ordered CuO nanofibrils synthesized through gas-solid reactions. J. Appl. Phys. 2004, 95, 5889–5895. [Google Scholar] [CrossRef]
- Kaur, M.; Muthe, K.P.; Despande, S.K.; Shipra, C.; Singh, J.B.; Neeika, V.; Gupta, S.K.; Yakh-mi, J.V. Growth and branching of CuO nanowires by thermal oxidation of copper. J. Cryst. Growth 2006, 289, 670–675. [Google Scholar] [CrossRef]
- Junfei, F.; Yimin, X. Investigation of optical absorption and photothermal conversion characteristics of binary CuO/ZnO nanofluids. RSC. Adv. 2022, 7, 56023–56033. [Google Scholar]
- Manjari, G.; Saran, S.; Arun, T.; Vijaya Bhaskara Rao, A.; Suja, P.D. Catalytic and recyclability properties of phytogenic copper oxide nanoparticles derived from Aglaia elaeagnoidea flower extract. J. Saudi. Chem. Soc. 2017, 21, 610–618. [Google Scholar] [CrossRef]
- Manoj, D.; Saravanan, R.; Santhanalakshmi, J.; Agarwal, S.; Gupta, V.K.; Boukherroub, R. Towards green synthesis of monodisperse Cu nanoparticles: An efficient and high sensitive electrochemical nitrite sensor. Sens. Actuators. B 2018, 266, 873–882. [Google Scholar] [CrossRef]
- Surapaneni, M.; Prachi, K.; Swati, C.; Nagarajan, P. Understanding the pathway of antibacterial activity of copper oxide nanoparticles. RSC Adv. 2015, 5, 12293–12299. [Google Scholar]
- Sathya, S.; Murthy, P.S.; Devi, V.G.; Das, A.; Anandkumar, B.; Sathyaseelan, V.S.; Doble, M.; Venugopalan, V.P. Antibacterial and cytotoxic assessment of poly (methyl methacrylate) based hybrid nanocomposites. Mater. Sci. Eng. C 2019, 100, 886–896. [Google Scholar] [CrossRef]
- Tulinska, J.; Mikusova, M.L.; Liskova, A.; Busova, M.; Masanova, V.; Uhnakova, I.; Rollerova, E.; Alacova, R.; Krivosikova, Z.; Wsolova, L.; et al. Copper Oxide Nanoparticles Stimulate the Immune Response and Decrease Antioxidant Defense in Mice After Six-Week Inhalation. Front. Immunol. 2022, 13, 874253. [Google Scholar] [CrossRef]
- Ahmed, F.H.; Tommy, S.H.; Vesselin, N.P. Strongly Enhanced Antibacterial Action of Copper Oxide Nanoparticles with Boronic Acid Surface Functionality. ACS. Appl. Mater. Inter. 2019, 11, 12232–12243. [Google Scholar]
- Mohammed, I.N.; Krishnan, K. Biosynthesis, characterization and antibacterial activity of copper oxide nanoparticles (CuO NPs) from actinomycetes. Biocatal. Agric. Biotechnol. 2018, 15, 56–62. [Google Scholar]
- Alavi, M.; Dehestaniathar, S.; Mohammadi, S.; Maleki, A.; Karimi, N. Antibacterial Activities of Phytofabricated ZnO and CuO NPs by Mentha pulegium Leaf/Flower Mixture Extract against Antibiotic Resistant Bacteria. Adv. Pharm. Bull. 2021, 11, 497–504. [Google Scholar] [CrossRef] [PubMed]
- Jadhav, S.; Gaikwad, S.; Nimse, M.; Anjali, R. Copper Oxide Nanoparticles: Synthesis, Characterization and Their Antibacterial Activity. J. Clust. Sci. 2011, 22, 121–129. [Google Scholar] [CrossRef]
- Jing, L.; Madie, S.; Shuai, S.; Ryan, S.K.; George, P.C. Physiological Effects of Copper Oxide Nanoparticles and Arsenic on the Growth and Life Cycle of Rice (Oryza sativa japonica ‘Koshihikari’). Environ. Sci. Technol. 2018, 52, 13728–13737. [Google Scholar]
- Sudhir, S.; Dnyaneshwar, R.; Aniket, G.; Rai, M. Biogenic copper nanoparticles promote the growth of pigeon pea (Cajanus cajan L.). IET Nanobiotechnology 2017, 11, 773–781. [Google Scholar]

| Name of the Sample | Cu 2p (eV) | O 1s (eV) | C 1s (eV) | ||
|---|---|---|---|---|---|
| Cu 2p3/2 | Cu 2p1/2 | ||||
| CC 100 | 934.88 | 954.48 | 531.18 | 284.18 | 288.38 |
| CC 110 | 934.48 | 954.28 | 531.08 | 284.28 | 287.88 |
| Material | Surface Area (m2/g) | Pore Volume | Pore Size (nm) | ||||
|---|---|---|---|---|---|---|---|
| t-Plot External Surface Area | Surface Area | t-Plot Micropore Volume (cm3/g) | BJH Adsorption Cumulative Volume of Pores (m2/g) | BJH Desorption Cumulative Volume of Pores (m2/g) | BJH Adsorption Average Pore Diameter (4V/A) | BJH Desorption Average Pore Diameter (4V/A) | |
| CC 100 | 13.0291 | 12.9758 | −0.000062 | 0.040396 | 0.040583 | 10.64 | 6.06 |
| CC 110 | 3.6874 | 2.4368 | −0.000483 | 0.017041 | 0.017084 | 17.08 | 13.03 |
| Bacterial Strains | Type of CuO NPs | Zone of Inhibition (mm) | |||
|---|---|---|---|---|---|
| Conc. of CuO NPs (µg/mL) | |||||
| 200 | 100 | 50 | 0 | ||
| S. aureus | CC 100 | 16.0 ± 1.0 | 13.0 ± 0.9 | 9.0 ± 0.4 | ND |
| CC 110 | 16.1 ± 0.9 | 19.3 ± 0.4 | 11.1 ± 1.2 | ND | |
| E. coli | CC 100 | 23.1 ± 2.3 | 21.0 ± 0.8 | 15.0 ± 0.8 | ND |
| CC 110 | 23.2 ± 1.3 | 19.5 ± 0.5 | 14.4 ± 0.5 | ND | |
Disclaimer/Publisher’s Note: The statements, opinions and data contained in all publications are solely those of the individual author(s) and contributor(s) and not of MDPI and/or the editor(s). MDPI and/or the editor(s) disclaim responsibility for any injury to people or property resulting from any ideas, methods, instructions or products referred to in the content. |
© 2023 by the authors. Licensee MDPI, Basel, Switzerland. This article is an open access article distributed under the terms and conditions of the Creative Commons Attribution (CC BY) license (https://creativecommons.org/licenses/by/4.0/).
Share and Cite
Rajamohan, R.; Raorane, C.J.; Kim, S.-C.; Ashokkumar, S.; Lee, Y.R. Novel Microwave Synthesis of Copper Oxide Nanoparticles and Appraisal of the Antibacterial Application. Micromachines 2023, 14, 456. https://doi.org/10.3390/mi14020456
Rajamohan R, Raorane CJ, Kim S-C, Ashokkumar S, Lee YR. Novel Microwave Synthesis of Copper Oxide Nanoparticles and Appraisal of the Antibacterial Application. Micromachines. 2023; 14(2):456. https://doi.org/10.3390/mi14020456
Chicago/Turabian StyleRajamohan, Rajaram, Chaitany Jayprakash Raorane, Seong-Cheol Kim, Sekar Ashokkumar, and Yong Rok Lee. 2023. "Novel Microwave Synthesis of Copper Oxide Nanoparticles and Appraisal of the Antibacterial Application" Micromachines 14, no. 2: 456. https://doi.org/10.3390/mi14020456
APA StyleRajamohan, R., Raorane, C. J., Kim, S.-C., Ashokkumar, S., & Lee, Y. R. (2023). Novel Microwave Synthesis of Copper Oxide Nanoparticles and Appraisal of the Antibacterial Application. Micromachines, 14(2), 456. https://doi.org/10.3390/mi14020456

